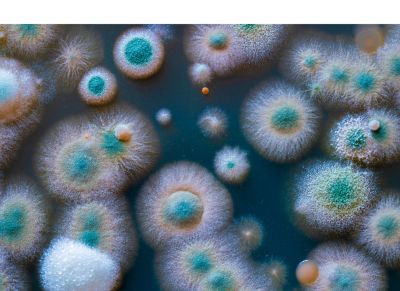
Petri plate with fungal colonies

Heterologous expression of natural products in fungal hosts
INTEREST AREA: Crop Protection
The advancement of sequencing, analytical and molecular tools has modernized natural products discovery. One area of research that has been a focus for natural products researchers is heterologous expression platforms of natural product biosynthetic gene clusters (BGCs) for production of cryptic or low-production compounds. Heterologous expression platforms have the potential to accelerate the discovery of novel chemistries. We seek to collaborate with the broader innovation community on heterologous expression platforms for natural products discovery by exploring the movement of BGCs of various sizes covering a range of natural product chemospace in fungal (filamentous fungi and yeast) heterologous hosts. Additionally, once production is achieved, we would like to understand how titer can be influenced to achieve relevant bioactivity.
At Corteva Agriscience, our goal is to develop effective, sustainable, and durable solutions to agricultural challenges. We invite public and private sector scientists to join in our efforts by submitting a proposal to demonstrate the transfer of and expression from large fungal biosynthetic gene clusters in heterologous fungal hosts.
Closed
Submission Deadline: November 30, 2021
Who Should Apply
Scientists in the public and private sector
Funding
Up to $50,000, including a maximum of 10% indirect costs*
What Are We Seeking?
We are seeking short, non-confidential proposals that describe a plan to demonstrate the transfer of and expression from large fungal biosynthetic gene clusters in a heterologous fungal (yeast or filamentous fungi) host, leading to detectable production of natural products.
Must haves:
- A heterologous fungal (yeast or filamentous fungi) expression system capable of producing natural products from various classes: e.g., non-ribosomal peptide, polyketide, terpenoids, etc.
- Demonstrated success in the transfer of and expression from fungal biosynthetic gene clusters comprised of >5 genes to a heterologous fungal host system
- Demonstrated success in the heterologous production of a natural product from at least one class
- Openness to jointly identify target BGCs with Corteva scientists, if your proposal is selected
Nice-to-haves:
- Demonstrated success in the heterologous production of natural products from multiple classes
Approaches not of interest:
-
Bacterial expression systems
-
Heterologous expression platforms lacking evidence of success for production of natural products
Proposals should include:
-
Detailed description of previous success in heterologous expression of at least one natural product molecule in fungal (yeast or filamentous fungi) hosts
-
A high-level timeline to proof of concept for the proposed heterologous fungal expression system supporting BGCs comprised of >5 genes (target BGCs to be jointly identified); ideally the proposed timeline would be within a 12-month period
- Expertise, equipment, and facilities you have and/or need to execute the proposal
- Description of potential roadblocks to success (including use of the proposed expression system by Corteva)
- A breakdown of the estimated project cost (up to $50,000 USD inclusive of a maximum of 10% indirect costs*)
Submitters must have the right to propose the technology described in the submission, or if submitting on behalf of an employer, be an authorized representative of the employer. Please review our full terms and conditions for participating in this Open Innovation Challenge.
Who Should Apply?
- Scientists with expertise in heterologous expression of natural products in fungal (yeast or filamentous fungi) hosts
- Public and private sector institutions and organizations with related experience and interest
What Should You Expect?
For submissions received by 5:00pm PDT, November 30, 2021:
We will evaluate your submission and notify you of its status by January 30, 2022.
An Open Innovation representative will contact selected finalists to arrange a virtual discussion with Corteva scientists under confidentiality and to provide additional details on the selection process.
For selected proposals:
Submitters will engage with Corteva scientists to jointly identify the BGC and develop a plan to test the proposed fungal heterologous expression platform in the transfer and expression of selected fungal biosynthetic gene clusters of various sizes and natural product classes.
How Can We Help?
Funding (up to $50,000 inclusive of a maximum of 10% indirect costs*)
Corteva in-kind resources as applicable
Opportunities for extended collaboration and additional funding if successful
* Indirect costs available to academic and nonprofit research institutes only
